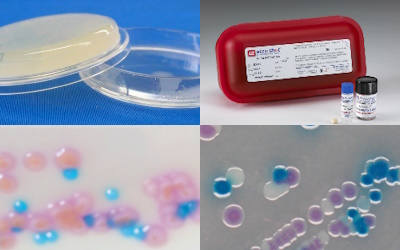

製品情報

試 薬
試薬=試験研究用の薬品は、研究機関はもちろんのこと、さまざまな産業分野で新たなプロダクトの誕生を支えています。また製造プロセスの効率化や、品質管理にも欠かせないものとなっています。

ライフサイエンス
総合試薬メーカーとして長年蓄積してきたノウハウや技術力を活かし、再生医療・細胞培養や遺伝子・タンパク質研究、その他バイオ研究にてお使い頂ける様々な試薬を提供しております。

微生物検査
病院での臨床検査や食品・環境の衛生検査などでお使いいただける培地をはじめ、精度管理に不可欠な標準菌株、分子疫学解析や遺伝子検出用のPCRキットなど、幅広い製品を取り揃えております。

ファインケミカル(化学品)・医薬・食添
試薬の製造で培った合成製造技術を用い、医薬品原薬、食品添加物、有機金属化合物など、様々な分野で求められる機能をもった製品を提供しています。 ご要望により受託製造も承っております。



システム・機材
実験・研究、各種分析に欠かせない多くの機材を提供しています。また、薬品管理システム「IASO」は国内で多くのユーザーに支持されてきた薬品管理のデファクトスタンダードシステムです。

製品検索サイト
(Cica-Web)
「SDS、規格書、試験成績書の入手」「製品詳細・在庫状況の確認」「Web上で製品のご注文」